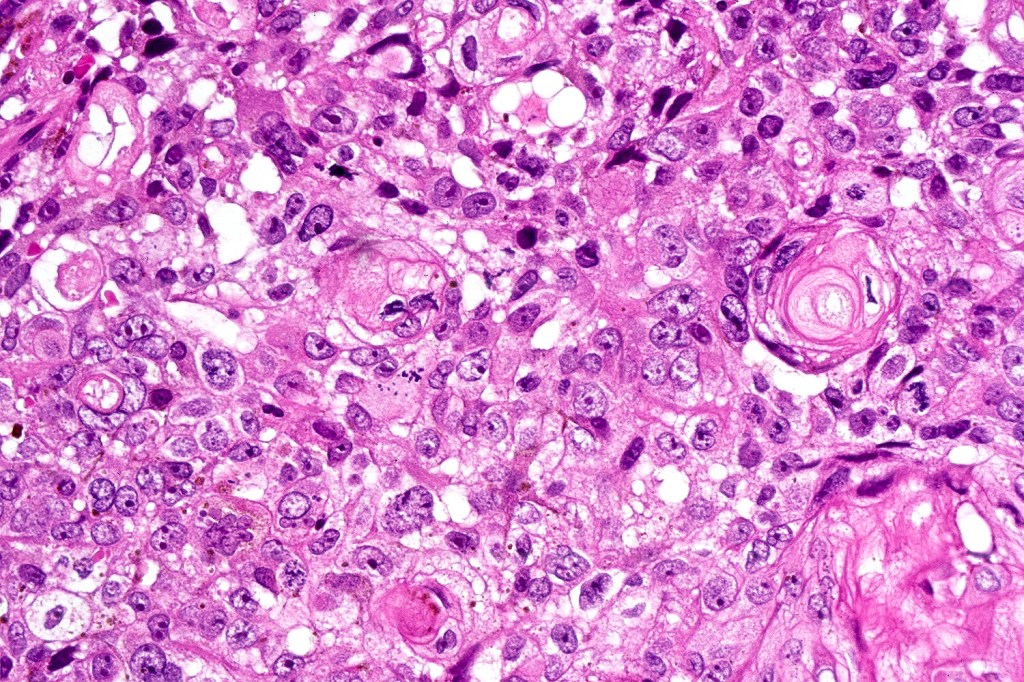
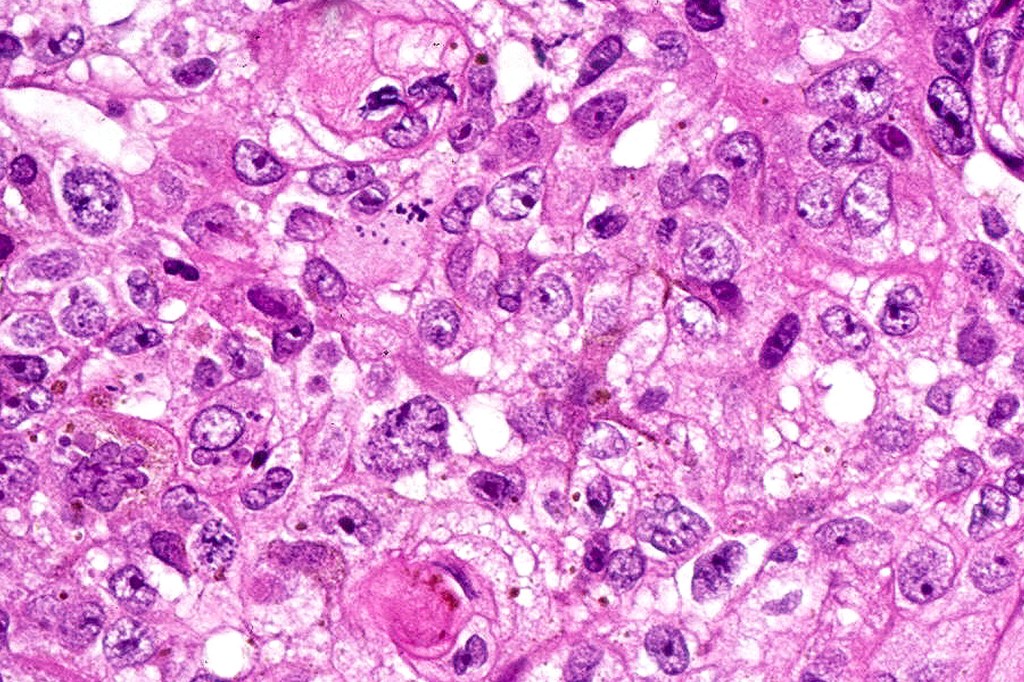
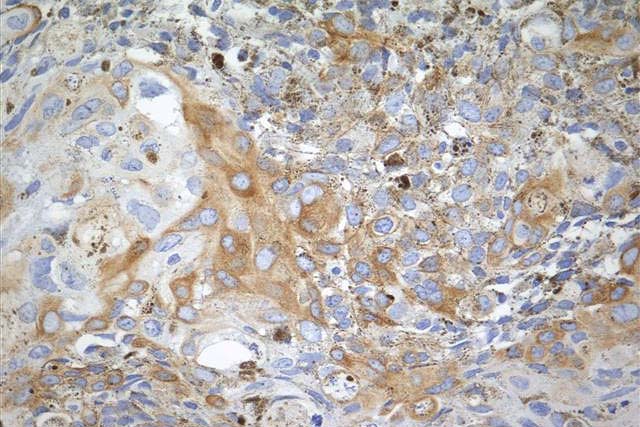

Clinical features
•Presents as a small pigmented papule or nodule on sun-damaged skin
•3m:1F
•28-92 years (mean 70)
•0.2-2.5 cm (mean 0.8) diameter
•Head, extremities, trunk in descending order of frequency
Rarely recurs
Histological features
•Well circumscribed nodular or multinodular growth pattern
•Admixture of basaloid matrical, supramatricial & eosinophilic shadow cells with dendritic melanocytes. The ghost cell change is distinctive affecting individual cells with preservation of their cytological detail rather than the en masse change typical of pilomatricoma
•Variable pleomorphism and mitotic activity affecting the matrical cells
•12 cases of the so-called malignant variant have been documented- characterized by ulceration, an infiltrative growth pattern and excessive mitotic activity- may recur but no evidence of metastatic disease or mortality has been reported

Immunohistochemistry (images from Professor Wayne Grayson’s case)
•Beta-catenin, P-cadherin, E-cadherin +ve
•AE1/AE3 (image1), CK5/6 positive
•Dendritic cells S100 (image 2), Melan-A, HMB45 +ve (image 3),

Differential diagnosis•Distinction from pigmented pilomatricoma is afforded by the pattern of ghost cell differentiation. In the former, it affects sheets of basaloid cells whereas in the latter, it develops in individual cells which retain their cell outline
•Basal cell carcinoma with matricial differentiation typicaly shows peripheral palisading, retraction artifact and mucin deposition
•While there is overlap with matricial carcinoma, the presence of necrosis, atypical mitoses, lymphovascular invasion & perineural infiltration are indicative of the latter diagnosis. In cases where doubt exists, the lesion should be fully excised and the patient follow-up very carefully.
If you like this blog, please subscribe and hit the like button. The blog is not fixed or written in tablets of stone. If you have a useful comment, it can be added to the text. If you have a case that you would like to add, please send it to me at phmckee1948@gmail.com Only perfectly stained and photographed at high resolution can be considered.
Leave a comment